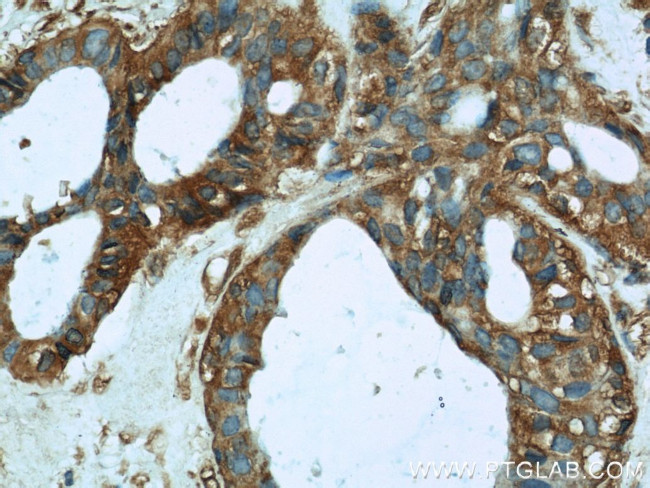
HTF9C Antibody in Immunohistochemistry (Paraffin) (IHC (P))
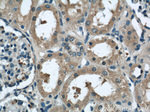
HTF9C Antibody in Immunohistochemistry (Paraffin) (IHC (P))

Search
Proteintech
HTF9C Polyclonal Antibody
{{$productOrderCtrl.translations['antibody.pdp.commerceCard.promotion.promotions']}}
{{$productOrderCtrl.translations['antibody.pdp.commerceCard.promotion.viewpromo']}}
{{$productOrderCtrl.translations['antibody.pdp.commerceCard.promotion.promocode']}}: {{promo.promoCode}} {{promo.promoTitle}} {{promo.promoDescription}}. {{$productOrderCtrl.translations['antibody.pdp.commerceCard.promotion.learnmore']}}
产品信息
16199-1-AP
种属反应
宿主/亚型
分类
类型
抗原
偶联物
形式
浓度
规格
纯化类型
保存液
内含物
保存条件
运输条件
产品详细信息
Immunogen sequence: DTVHIPEAT KQVVKAFQEF IRSTPYSAYD PETYTGHWKQ LTVRTSRRHQ AMAIAYFHPQ KLSPEELAEL KTSLAQHFTA GPGRASGVTC LYFVEEGQRK TPSQEGLPLE HVAGDRCIHE DLLGLTFRIS PHAFFQVNTP AAEVLYTVIQ DWAQLDAGSM VLDVCCGTGT IGLALARKVK RVIGVELCPE AVEDARVNAQ DNELSNVEFH CGRAEDLVPT LVSRLASQHL VAILDPPRAG LHSKVILAIR RAKNLRRLLY VSCNPRAAMG NFVDLCRAPS NRVKGIPFRP VKAVAVDLFP QTPHCEMLIL FERVEHPNGT GVLGPHSPPA QPTPGPPDNT LQETGTFPSS (277-625 aa encoded by BC013352)
靶标信息
The protein encoded by TRMT2A is of unknown function. However, it is orthologous to the mouse Trmt2a gene and contains an RNA methyltransferase domain. Expression of TRMT2A varies during the cell cycle, with aberrant expression being a possible biomarker in certain breast cancers. Several transcript variants encoding two different isoforms have been found for TRMT2A.
仅用于科研。不用于诊断过程。未经明确授权不得转售。
生物信息学
蛋白别名: Em:AC006547.2; HpaII tiny fragments locus 9c; HpaII tiny fragments locus 9c protein; mRNA (uracil-5-)-methyltransferase TRMT2A; TRM2 tRNA methyltransferase 2 homolog A; tRNA (uracil-5-)-methyltransferase homolog A; tRNA methyltransferase 2 homolog A; unnamed protein product
基因别名: Htf9-c; HTF9C; TRMT2A
UniProt ID: (Human) Q8IZ69, (Mouse) Q8BNV1
Entrez Gene ID: (Human) 27037, (Rat) 287953, (Mouse) 15547